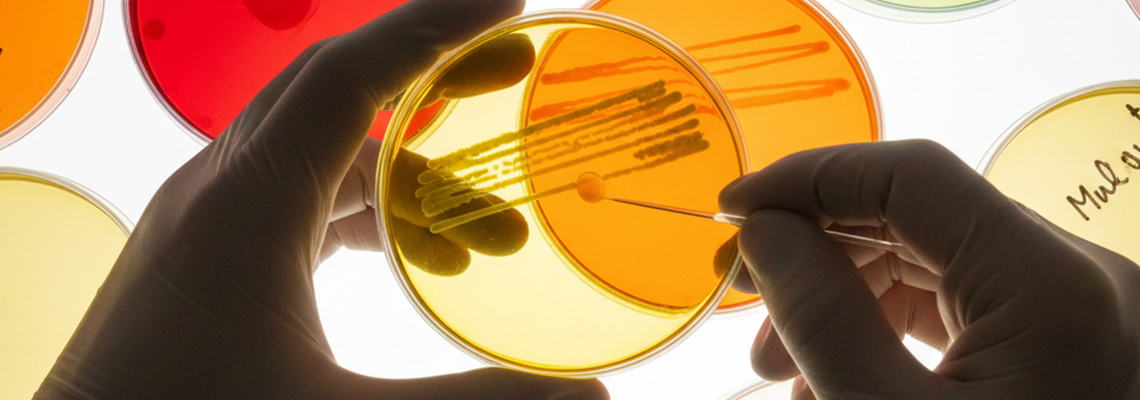
O futuro das doenças raras: coordenação, inovação e acesso

Oferecido por
As doenças raras atravessam um momento decisivo no Brasil. De um lado, emergem novas terapias, tecnologias diagnósticas e modelos de cuidado capazes de encurtar jornadas e transformar prognósticos. De outro, persistem entraves estruturais que impedem que esses avanços cheguem às pessoas no tempo necessário.
Entre regulação, capacidade de resposta do SUS, modelos de avaliação tecnológica e lacunas de coordenação, o futuro ainda depende de mudanças profundas.
No novo episódio do podcast de Biotech and Health, com patrocínio da PTC Therapeutics Brasil, a repórter Carolina Abelin conversa com Antoine Daher, fundador e presidente da Casa Hunter, sobre os caminhos necessários para aproximar inovação, política pública e vida real do paciente.
Daher discute a importância de alinhar Conitec, Anvisa, Ministério da Saúde e demais instâncias decisórias, além de fortalecer centros de referência, ampliar a capacitação profissional e avançar em modelos de avaliação que incluam dados de mundo real e considerem a especificidade das doenças raras.
A conversa reforça que acesso, inovação e equidade são dimensões inseparáveis, e que transformar o futuro das doenças raras exige ação coordenada, diálogo entre governo, especialistas, indústria, Congresso Nacional e sociedade civil organizada.
Ouça no seu agregador de Podcast favorito: